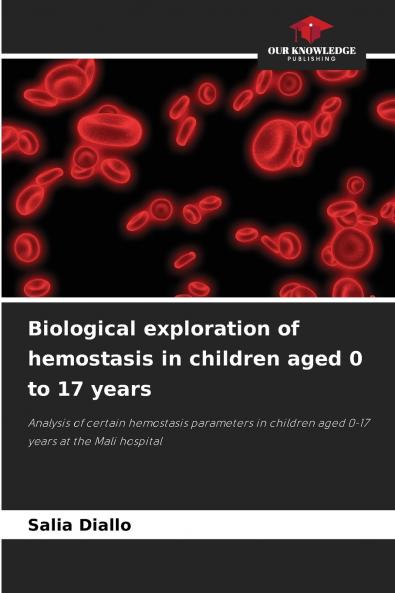
Biological exploration of hemostasis in children aged 0 to 17 years

English
Paperback
₹5177
(All inclusive*)
Delivery Options
Please enter pincode to check delivery time.
*COD & Shipping Charges may apply on certain items.
Review final details at checkout.
Looking to place a bulk order? SUBMIT DETAILS
About The Book
Description
Author
Hemostasis encompasses all the mechanisms involved in stopping bleeding. When a blood vessel is breached the body's task is to repair it. Certain parameters such as prothrombin time International Normalized Ratio and activated partial thromboplastin time play a role in both the diagnosis and therapeutic monitoring of this pathology. The aim of this study was to investigate haemostasis in children aged 0 to 17 years. The parameters studied were prothrombin rate (PT) INR and activated partial thromboplastin time or kaolin (aPTT/TCK). 100 patients were included 57% of them male and 43% female. The majority of these patients came from Commune 6 (61%) 16% from Commune 5 10% from the outskirts of Bamako (i.e. patients outside the communes of Bamako) 8% from Commune 1 and 5% from Commune 4. With regard to the reasons for prescribing haemostasis it emerged that this parameter was prescribed in patients mainly for preoperative assessment (90% of cases). This analysis was also suggested in cases of suspected infection (4%).
Delivery Options
Please enter pincode to check delivery time.
*COD & Shipping Charges may apply on certain items.
Review final details at checkout.
Details
ISBN 13
9786208924621
Publication Date
-31-05-2025
Pages
-52
Weight
-85 grams
Dimensions
-152x229x3.16 mm